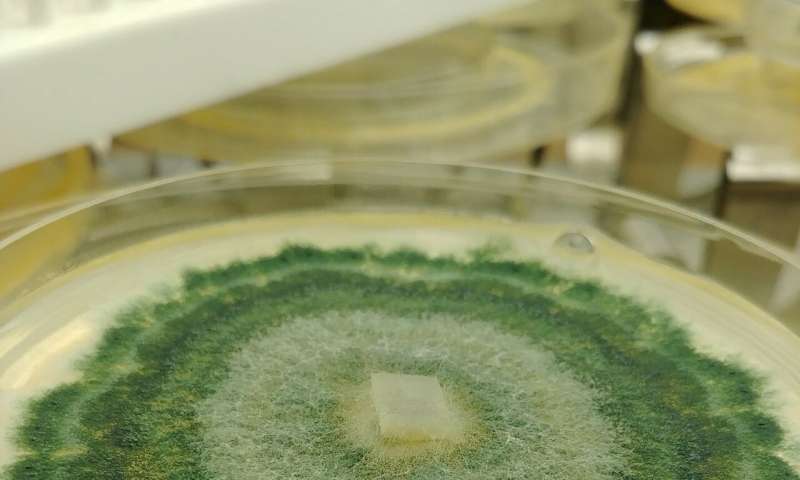

식물은 질병이 발생하면 자가격리를 할 수 없지만, 친구의 도움을 받을 수는 있다. 이로운 토양 미생물이 여러 질병을 예방하는 데 도움이 되기 때문이다. 미국 텍사스 A&M AgriLife의 과학자들은 옥수수가 병원균을 방어하는 데 이로운 균류가 어떻게 도움을 주는지 밝혔다.
그 결과가 The Plant Cell 1월호에 발표되었다. 연구를 주도한 것은 텍사스 A&M 대학 농생명과학의 식물병리학 및 미생물학 박사 Michael Kolomiets 씨이다. 연구비는 미국 농무부 국립 식량농업원(National Institute for Food and Agriculture)에서 제공했다. 결과적으로, 식물 면역의 신비한 측면을 밝히고 더 생산적인 곡식 작물의 연구를 가능하게 한다.
신중히 작물을 선발, 육종하면 수확량과 내성, 질병 저항성이 높아져 전 세계의 작물이 크게 개량된다. 하지만 Kolomiets 씨는 오늘날 유전자 선발만으로는 작물의 생산성을 크게 개선시키기 힘들다고 한다.
그는 "현재 가장 중요한 다음 전략으로 여겨지는 건 우리가 '갈색 혁명'이라 부르는 것입니다. 토양에 서식하는 이로운 미생물에게서 도움을 받을 수 있어요."라고 한다.
토양 미생물은 '침투성 저항성'을 유발한다
토양 미생물은 놀라운 방식으로 식물에 영향을 미친다. 예를 들어, 식물이 질병과 싸우면 성장이 둔화된다. 하지만 식물의 뿌리에 이로운 균류가 있으면 정상적으로 성장하면서 질병과 맞설 수 있다.
이들 토양 미생물은 식물을 질병에서 보호하는 특별한 역할을 한다. 토양 미생물이 존재하면 식물은 광범위한 병원균으로부터 면역력을 높이는 "유도된 침투성 저항성(Induced systemic resistance)"이라 부르는 걸 받는다.
Kolomiets 씨는 "병원균에 저항성을 가진 작물을 설계할 때, 우린 보통 각각의 특정한 균주나 병원균 집단에 대한 저항성을 식별해야 합니다."라고 한다. "유도된 침투성 저항성은 다양한 병원균에 효과적이기에 훨씬 좋은 전략이죠."
이러한 이유로 식물과 미생물의 상승 효과를 이해하면 작물의 건강과 수확량을 향상시킬 수 있는 가능성이 있다.
미생물은 정확히 어떤 일을 하는가?
과학자들은 미생물이 식물에 미치는 영향이 재스몬산이라 부르는 식물 호르몬과 관련되어 있다는 걸 알고 있었지만, Kolomiets 씨에게 그 그림은 이치에 맞지 않았다. 호르몬은 방어력을 높이는 반면 성장을 늦춘다. 이 때문에 식물은 식물의 조직에 이 호르몬이 지속적으로 존재하면 성장에 불리해지기에 스트레스를 감지하는 짧은 시간 동안에만 재스몬산을 생산한다.
그는 식물이 생존하는 동안 뿌리에 상주하는 이로운 균류가 식물이 늘 재스몬산을 생산하게 하는데, "균류가 어떻게 식물의 성장도 촉진하는지 늘 궁금했습니다. 이해가 되지 않았죠."라고 한다.

수액에 관한 모든 것
균류가 있든 없든, 옥수수 내부에서 무슨 일이 일어나는지 확인하기 위해 연구진은 뿌리에 트리코데르마균이 있는 옥수수에서 수액을 채취했다. 그 다음 연구진은 이 "강력한" 수액을 트리코데르마균과 접촉하지 않은 옥수수에 주입했다.
또한 연구진은 이전 연구에서 발견된 두 가지 이상의 옥수수 품종으로 이 실험을 반복했다. 첫번째 품종은 트리코데르마균이 없어도 자연적으로 더 강한 면역력을 가지고 있었다. 이와 반대로 두번째 품종은 면역력이 약했다. 마지막으로 연구진은 이전에 발견된 두 가지 트리코데르마균의 돌연변이로 실험을 반복했다. 한 돌연변이는 옥수수의 면역력을 향상시키지 못했고, 다른 하나는 야생형 조상보다 더 높은 수준의 면역력을 유도했다.
면역력이 강한 식물에서 채취한 수액을 면역력이 정상 또는 약한 식물에 주입한 모든 사례에서 수액은 백신과 유사하게 작용해 면역력이 약한 식물이 질병에 저항성을 갖도록 만들었다. 그리고 면역력이 약한 식물의 수액이 향상된 식물에 주입되면 면역력이 약해졌다.
부분의 합과 다른 물질
다음으로, 연구진은 각각의 실험에서 식물 내의 완전한 대사 산물들을 분석했다. 최종 분석에서, 두 가지 화합물이 트리코데르마균의 효과를 해명했다. 12-OPDA라는 한 화합물은 재스몬산과 친숙한 구성요소이다. 그러나 재스몬산과 달리 이 화합물은 식물의 성장을 방해하지 않는 듯하다.

또한, 분석 결과 트리코르데마균은 식물이 12-OPDA를 생산하도록 장려하고 12-OPDA를 활용하며 재스몬산을 만들지 않도록 하는 화학 신호를 보낸다는 것이 밝혀졌다.
Kolomiets 씨는 "사람들은 이러한 다단계의 경로를 단일한 사건이라 생각합니다. 하지만 중간 과정이 마지막 결과만큼 중요하단 사실이 밝혀졌습니다."라고 한다. 그 결과는 더 튼튼한 식물을 육종하려는 식물 육종가들이 이러한 중간 과정이 변경된 옥수수 품종을 구할 수 있단 것을 시사한다.
옥수수와 미생물이 함께 더 잘 작용할 수 있는가?
연구진의 목표 가운데 하나는 현재 이용되는 트리코르데마균보다 훨씬 더 유용한 자연적 변형을 찾는 일이다. Kolomiets 씨는 "자연에는 광범위한 다양성이 있으며, 우린 그 다양성을 이용해야 합니다."라고 한다.
또한 Kolomiets 씨는 연구진이 "이러한 이로운 미생물과 더 잘 상호작용하는 옥수수 품종을 찾을 수 있습니다."라고 한다. "우리가 그들이 어떻게 작용하는지만 안다면, 미생물에게 더 나은 옥수수를 생산하고 옥수수에게는 더 나은 미생물을 생산할 수 있어서 현장에 더 건강한 옥수수를 내놓게 됩니다."
https://phys.org/news/2020-04-soil-microbes-resist-disease.html
'농담 > 농-생태계' 카테고리의 다른 글
| 브라질의 아마존이 더욱더 빠르게 파괴되고 있다 (0) | 2020.10.03 |
|---|---|
| 생태계의 동적 평형 (0) | 2020.10.03 |
| 좋은 흙의 중요성 (0) | 2020.01.16 |
| 나무와 토양침식 (0) | 2019.12.31 |
| 흙의 역습, 지구의 경고 (0) | 2019.12.06 |